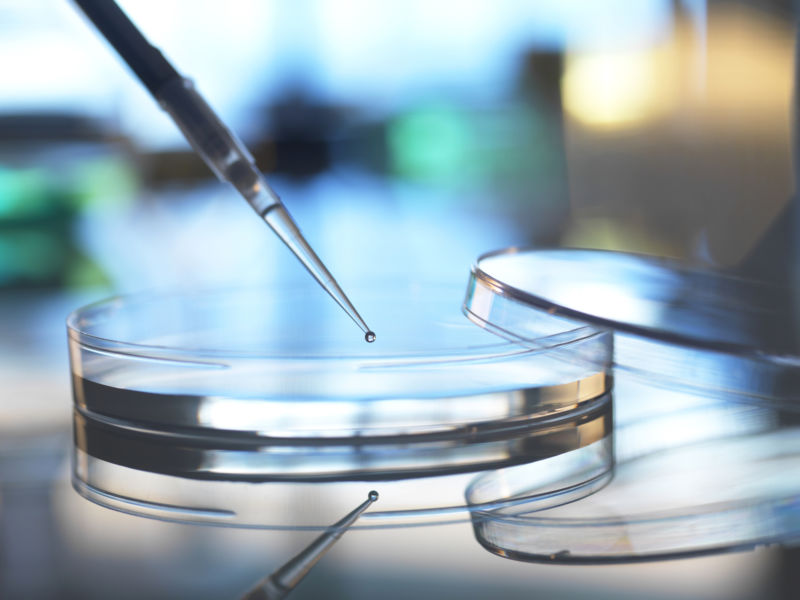
New study suggests women may be getting less money to start labs

Enlarge (credit: Andrew Brooks | Getty Images)
A researcher’s most important grant is often the first one. These grants provide the money for critical equipment and pay for technicians, graduate students, and post-graduate researchers—the key ingredients to successful labs. Because of all it enables, getting that first grant is an essential step toward launching a research career. As a result, problems in our system that bias who gets these grants may have an outsized influence on the trajectory of research.
But that’s exactly what a new study in JAMA seems to have found. While first-time grants in the biosciences are given to men and women at roughly even numbers, the male grant recipients tend to get more money from the same number of grants. While the situation definitely appears to be problematic, there are some subtleties in the data that suggest the situation is complex and that this isn’t an across-the-board problem. The disparities are still large enough that they could be contributing to disparities in the research community.
Start me up
When a university or research center hires a new faculty member, it promises them little more than a bit of unoccupied lab space and some money. Every bit of research the new faculty wants to do requires equipment and consumables like chemicals and enzymes. And since they’ll be busy writing grants and teaching, they need to hire some people to actually start doing the research. The money provided by the university helps greatly in this regard, but it tends to run out quickly if there’s any expensive equipment involved.
Read 11 remaining paragraphs | Comments
Source: Ars Technica – New study suggests women may be getting less money to start labs
